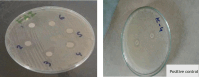

Synthesis and evaluation of vanillin Schiff bases as potential antimicrobial agents against ESBL-producing bacteria: towards novel interventions in antimicrobial stewardship
- PMID: 39543243
- PMCID: PMC11564564
- DOI: 10.1038/s41598-024-78302-9
Synthesis and evaluation of vanillin Schiff bases as potential antimicrobial agents against ESBL-producing bacteria: towards novel interventions in antimicrobial stewardship
Abstract
The escalating challenge of antimicrobial resistance necessitates the development of novel antibacterial agents. In this study, a series of five vanillin Schiff bases (SB-1 to SB-5) were synthesized from vanillin and various aromatic amines. The chemical structures of these compounds were characterized using Thin Layer Chromatography (TLC), Fourier Transform Infrared Spectroscopy (FT-IR), proton nuclear magnetic resonance ( -NMR), carbon-13 NMR ( -NMR), and mass spectrometry techniques. Antibacterial efficacy was evaluated against strains of bacteria producing extended-spectrum beta-lactamases (ESBL), including Escherichia coli, Pseudomonas aeruginosa, and Klebsiella pneumoniae using the disc diffusion method. Cytotoxic effects were assessed through haemocompatibility and brine shrimp lethality assays. The Schiff bases demonstrated notable antibacterial activities, with SB-1, SB-2, SB-4, and SB-5 exhibiting zones of inhibition up to 16.0, 16.5, 16.6, and 15.5 mm against ESBL E. coli, respectively. SB-3 showed a maximum inhibition zone of 15.0 mm against ESBL K. pneumoniae. In cytotoxicity assays, the compounds exhibited IC values against red blood cells (RBCs) greater than 200 μg/mL and ranging from 45.7 to 50.5 μg/mL for the brine shrimp assay. While demonstrating potent antibacterial properties, the toxicity towards human RBCs suggests that further toxicity evaluations and structural modifications are essential for developing safer therapeutic agents based on vanillin Schiff bases.
Keywords:
© 2024. The Author(s).
Conflict of interest statement
Figures

References
-
- Uddin, T. M. et al. Antibiotic resistance in microbes: History, mechanisms, therapeutic strategies and future prospects. J. Infect. Public Health14(12), 1750–1766 (2021). - PubMed
-
- Bai, H., Liu, T., Wang, H., & Wang, Z. Antibacterial characteristics and mechanistic insights of combined tea polyphenols, nisin, and epsilon-polylysine against feline oral pathogens: a comprehensive transcriptomic and metabolomic analysis. J. Appl. Microbiol., lxae189 (2024) - PubMed
-
- Kabir, E. & Uzzaman, M. A review on biological and medicinal impact of heterocyclic compounds. Results Chem.4, 100606 (2022).
MeSH terms
Substances
LinkOut - more resources
Full Text Sources
Medical

